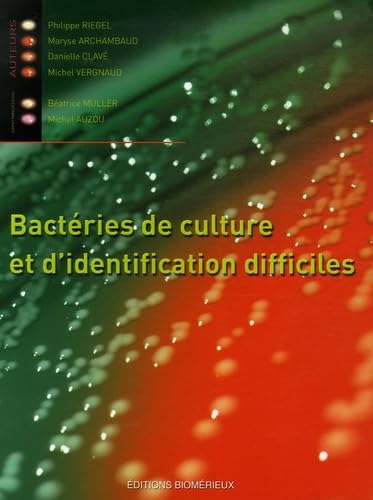
Bactéries de culture et d identification difficiles

- Retour
- Tous les ouvrages
- Théâtre
- Littérature française
- Poésie
- Livres de référence
- Littérature anglaise
- Romans historiques
- Littérature humoristique
- Récits de voyages
- Littérature italienne
- Antiquité
- Correspondances et mémoires
- Autres littératures étrangères
- Littérature japonaise
- Littérature américaine
- Biographies
- Littérature russe
- Littérature espagnole
- Retour
- Tous les ouvrages
- Castor poche junior
- Castor benjamin-cadet
- Nathanpoche 6-8 ans
- Première Bibliothèque Rose
- Bibliothèque Rose
- Casterman
- Pocket jeunesse
- Belles histoires
- Bayard-Je bouquine
- Folio junior
- Livre de poche jeunesse
- Bibliothèque verte
- Nathanpoche
- Folio benjamin
- Folio cadet
- J'aime lire
- La cabane magique
- Retour
- Tous les ouvrages
- Histoire de l'art
- Peinture
- Techniques de l'art
- Musique
- Danse
- Photographie
- Architecture
- Design
- Théâtre
- Musées et expositions
- Art mural - Graffitis - Tags
- Cinéma
- Beaux livres
- Mode
- Cirque
- Marché de l'art
- Art mondial
- Arts populaires
- Critique d'art
- Sculpture
- Les Classiques de l'art
- Retour
- Tous les ouvrages
- Médecine
- Sciences pour tous
- Agriculture - Agroalimentaire
- Mathématiques
- Sciences de la vie - Biologie - Génétique
- Sciences de la terre - Eau - Environnement
- Histoire des sciences
- Astronomie
- Bâtiment - Travaux publics - Matériaux
- Personnages scientifiques
- Physique - Sciences de la matière
- Techniques industrielles
- Chimie
- Sciences vétérinaires
- Artisanat
- Chaos
- Retour
- Tous les ouvrages
- Bouddhisme
- Islam
- Catholicisme
- Théologie
- Mysticisme
- Religion et société
- Bible
- Dictionnaires et encyclopédies
- Histoire des religions
- Protestantisme
- Hindouisme
- Judaïsme
- Art religieux
- Christianisme
- Sagesses orientales
- Orthodoxie et Églises d'Orient
- Taoïsme et Confucianisme
- Dialogue interreligieux
- Exégèse
- Shinto
- Vaudou, chamanisme et animisme
- Paranormal et parapsychologie
- Esotérisme et Paranormal
- Kabbale, gnose et occultisme
- Franc-maçonnerie et compagnonnage
- Egypte et le Livre des Morts
- Yi King
- Feng-Shui
- Retour
- Tous les ouvrages
- Auteurs initiés et magie en littérature
- Mythes et légendes
- Astrologie et arts divinatoires
- Kabbale, gnose et occultisme
- Magie et sorcellerie
- Franc-maçonnerie et compagnonnage
- Rêves, symboles et runes
- Ouvrages de référence
- Rose-Croix, Cathares et Templiers
- Magnétisme, radiesthésie et sourciers
- Au-delà, spiritisme et réincarnation
- Feng Shui
- Paranormal et parapsychologie
- Extraterrestres et ovnis
- Nostradamus et prophéties
- Alchimie
- Celtes et druides
- Théosophie
- Anges et angéologie
- Lieux spirituels
- Egypte
- Vampires, fantômes, fées et autres créatures
- Cristaux, pierres et couleurs
- Voyage astral
- Atlantide, pyramides et grandes énigmes
- New Age
- Hypnose et télépathie
- Exorcisme
- Mysticisme
- Retour
- Tous les ouvrages
- Shôjo manga (sentimental)
- Fantastique
- Manhwa (manga coréen)
- Science-fiction et Terreur
- Aventure
- Littérature, Histoire et Philosophie
- Arts martiaux et Combats
- Heroïc-Fantasy
- Érotisme (Hentai)
- Artbooks, livres techniques et généralités
- Humour
- Thriller et Suspense
- Sports
- Histoires courtes et One shots
- Retour
- Tous les ouvrages
- Programmation et langages
- Internet
- Entreprise
- Multimédia et graphisme
- Matériel
- Systèmes d'exploitation
- Jeux
- Bureautique et publication
- Bases de données
- Réseaux et télécommunication
- Linux et logiciels libres
- Sécurité informatique
- Intelligence artificielle
- Intranet
- Certifications
- Cyberculture
- Retour
- Tous les ouvrages
- Bases de la cuisine
- Desserts
- Cuisine au quotidien
- Cuisines du monde
- Cafés, thés, chocolats
- Gastronomie
- Vins
- Art de la table, Fêtes et Réceptions
- Légumes
- Poissons et Fruits de mer
- Fromages
- Entrées
- Alcools et spiritueux
- Cuisine de saison
- Cuisines régionales
- Pâtes, riz
- Cuisiniers vus à la télé
- Viandes, volailles, gibiers
- Beaux livres
- Régime spécial
- Retour
- Tous les ouvrages
- Maladies et dépendances
- Alimentation, régimes et diététique
- Beauté, forme et détente
- Guides pratiques
- Femmes
- Hommes
- Médecines douces
- Santé des femmes
- Santé des hommes
- Beauté, soins et style
- Psychologie et psychanalyse
- Dépendances et guérison
- Vieillissement
- Santé des enfants
- Santé mentale
- Exercice et fitness
Livres de Microbiologie d’occasion
Découvrez tous nos livres d'occasion en ligne dans la catégorie microbiologie. Remplissez votre panier et vos étagères avec de nouvelles lectures passionnantes : faites votre commande parmi des centaines de titres en microbiologie à petit prix sur RecycLivre, avec livraison partout dans le monde ! Des livres de la catégorie microbiologie à donner ? Retrouvez toutes nos solutions de collecte sur cette page. Vous préférez vous faire un peu d'argent et vendre vos livres de seconde main ? Rendez-vous sur notre application de rachat de livres, RecycLivre Rachète ! Lire la suite En voir moins
Recevez des inspirations littéraires, nos bons plans à petit prix et nos actus pour démocratiser l’occasion 🤍
Votre e-mail servira uniquement à vous envoyer la newsletter Recyclivre et ne sera jamais communiqué à un tiers. Vous pourrez vous désabonner en un clic à tout moment.